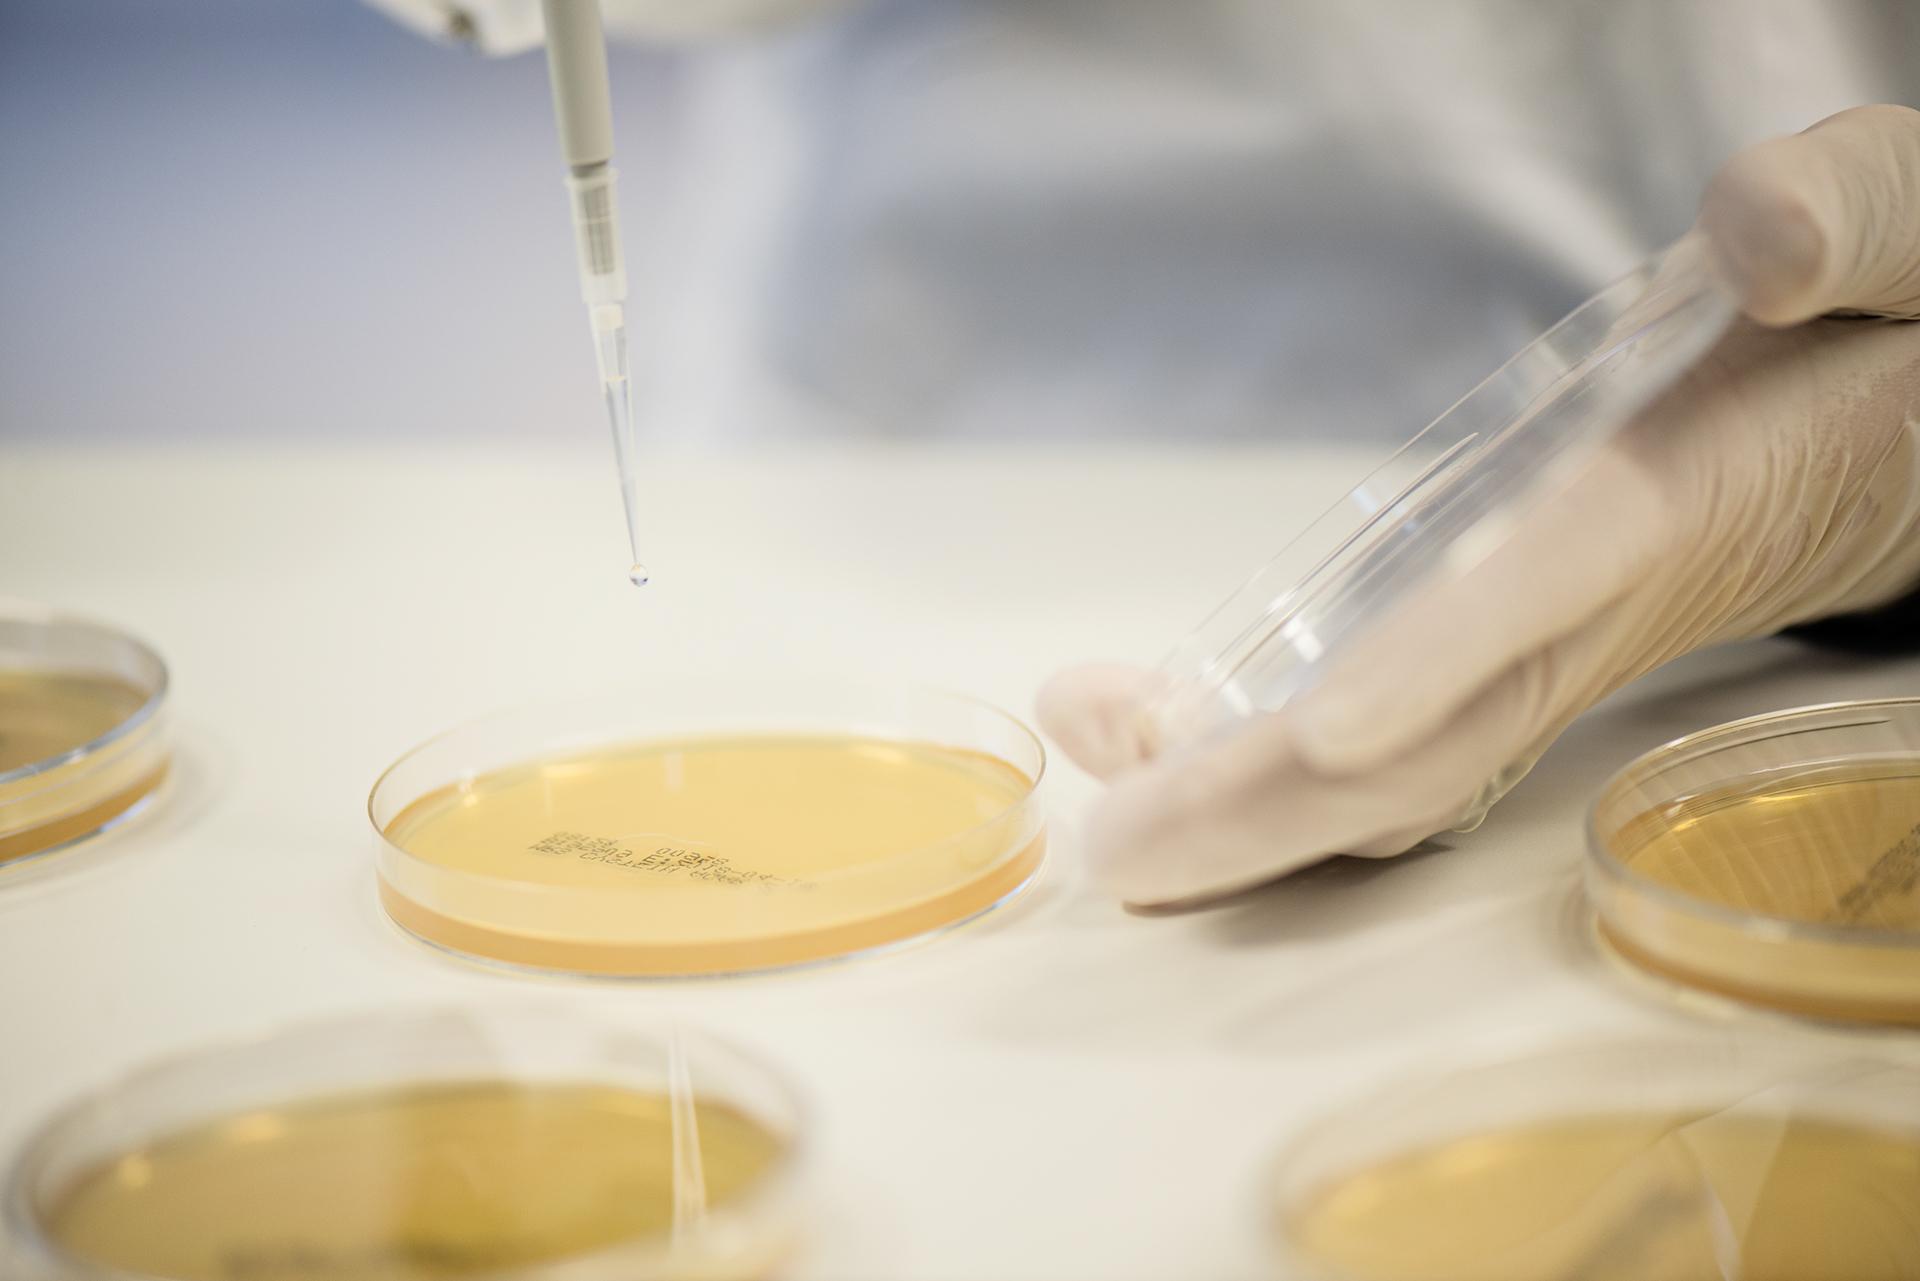

Từ Thụy Điển đến toàn cầu: Hành trình của một thương hiệu phát triển từ nền tảng khoa học
BioGaia là công ty chăm sóc sức khỏe hàng đầu thế giới, được thành lập tại Thụy Điển năm 1990, với định hướng phát triển dựa trên phương châm: khoa học là nền tảng tạo nên sản phẩm chất lượng. Phía sau mỗi sản phẩm BioGaia là hàng trăm nghìn giờ nghiên cứu của các nhà khoa học để tìm ra giải pháp tốt nhất cho hệ tiêu hóa và miễn dịch của trẻ nhỏ.
Khu vực các nhà khoa học dành hàng nghìn giờ để nghiên cứu sản phẩm
Trong suốt 35 năm qua, BioGaia đã luôn giữ vững tiêu chí này. Nhờ sự kiên định đó, mà ngày nay BioGaia đã mở rộng phạm vi có mặt trên toàn cầu, bao gồm những thị trường với tiêu chuẩn kiểm định khắt khe và khó tính như Châu Âu, Hoa Kỳ, Nhật Bản, Đức, Hàn Quốc,…
BioGaia – Lựa chọn của hàng triệu gia đình trên thế giới
Trong một thế giới mà lựa chọn ngày càng nhiều nhưng niềm tin lại ngày càng khan hiếm, BioGaia vẫn giữ vững một vị thế riêng, đại diện cho một sản phẩm an toàn, hiệu quả và đạt tiêu chuẩn chất lượng cao, được hàng triệu gia đình trên thế giới tin tưởng.
Chỉ riêng năm 2024, sản phẩm của BioGaia AB đã đạt doanh thu ước tính hàng trăm triệu USD, phần lớn đến từ dòng sản phẩm BioGaia Protectis dành cho trẻ em. Đây là một con số cho thấy rõ vị thế tiên phong của BioGaia trong ngành men vi sinh chất lượng cao dành cho trẻ sơ sinh.
Một trong những sản phẩm chủ lực của BioGaia là thực phẩm bảo vệ sức khỏe BioGaia Protectis với thành phần chính chủng lợi khuẩn L. reuteri DSM 17938 được phân lập từ sữa mẹ rất an toàn và lành tính có thể bổ sung được cho cả nhóm đối tượng nhạy cảm nhất là trẻ sinh non, trẻ sơ sinh, phụ nữ mang thai và đang cho con bú.
Ngoài ra, BioGaia có rất nhiều nghiên cứu chỉ ra rằng việc bổ sung lợi khuẩn đúng cách có thể giúp:
– Cân bằng hệ vi sinh đường ruột, hỗ trợ làm giảm tình trạng rối loạn tiêu hóa: tiêu chảy, táo bón, đầy hơi, khó tiêu,..
– Hỗ trợ cải thiện tình trạng khóc dạ đề (Colic), nôn trớ ở trẻ sơ sinh
– Hỗ trợ làm giảm tác dụng phụ của kháng sinh

Kho lưu trữ sản phẩm BioGaia Protectis tại Thụy Điển
10 năm BioGaia tại Việt Nam – Một hành trình kiến tạo niềm tin với mẹ Việt
BioGaia chính thức được phân phối tại Việt Nam từ năm 2015, tính đến nay là vừa tròn 10 năm. Mười năm không phải là quãng thời gian dài, nhưng là cột mốc đặc biệt ghi dấu một chặng đường đồng hành của BioGaia cùng các ba mẹ Việt trong giai đoạn quan trọng nhất của hành trình nuôi con trong những năm tháng đầu đời.

Hội thảo chuyên đề và chính thức ra mắt sản phẩm BioGaia Protectis tại Việt Nam
Sự phát triển bền vững và tăng trưởng liên tục qua nhiều năm không phải là điều mà bất kỳ thương hiệu nào cũng có thể đạt được. Nhưng BioGaia chính là minh chứng điển hình, nhờ nền tảng khoa học vững chắc và định hướng phát triển nhất quán. Trong bối cảnh khoa học và công nghệ không ngừng đổi mới, BioGaia vẫn giữ vững vai trò là người bạn đồng hành đáng tin cậy của hàng trăm nghìn gia đình Việt suốt một thập kỷ qua. Đây chính là kết quả của niềm tin, được xây dựng bằng chất lượng thực sự, bằng hiệu quả cảm nhận rõ rệt và bằng sự thấu hiểu sâu sắc những trăn trở của người mẹ khi chăm sóc hệ tiêu hóa non nớt của trẻ.
Với nền tảng khoa học vững chắc và hành trình phát triển bền vững trên toàn cầu, BioGaia đang từng bước củng cố vai trò trở thành một trong những thương hiệu men vi sinh hàng đầu tại Việt Nam nơi niềm tin của mẹ luôn bắt đầu từ điều nhỏ nhất: sự khỏe mạnh của hệ tiêu hóa.
Lưu ý: Sản phẩm này không phải là thuốc và không có tác dụng thay thế thuốc chữa bệnh. Tham khảo ý kiến chuyên gia y tế trước khi sử dụng.
Thông tin liên hệ:
Công ty TNHH Công nghệ BioVagen Việt Nam
Lô đất số 01, CN8 Cụm công nghiệp Từ Liêm, Phường Xuân Phương, Thành phố Hà Nội, Việt Nam
Tham khảo link sản phẩm chính hãng tại đây .






